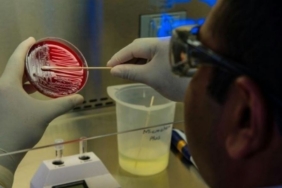
site foto ölcusu (61)

Son Gelişmeler
- 17:11 FIFA’dan Ofsayt Kuralında Devrim Niteliğinde Onay
- 17:01 Katar’da Enerji Tesisleri Saldırıya Uğradı: Avrupa’da Doğalgaz Fiyatlarında Sert Artış
- 16:47 Emeklilere Bayram İkramiyesinde Bu Yıl Artış Gelmeyecek
- 16:44 Bedelli Askerlik Ücretine Resmî Zam Geliyor
- 22:31 Yurt dışından telefon getirmenin maliyeti 57 bin lira oldu
USD39,73
%0.15
EURO45,73
%-0.12
GBP53,45
%0.06
BIST9.128,91
%-0.81
GR. ALTIN4.283,86
%-0.31
Hızlı Erişim
Son Dakika
Günün son gelişmelerine yakından bakın.
Covid 19
Pandeminin detayları..
Döviz Kurlar
Piyasanın kalbine yakından göz atın.
Kripto Paralar
Kripto para piyasalarında son durum!
Hava Durumu
Maç Merkezi
Puan Durumu
Gazeteler
Günün gazete manşetlerini inceleyin.
Canlı Tv
Emtia
Emtia'larda son durum!
Namaz Vakitleri
Yol Durumu
Bu web sitesinde en iyi deneyimi yaşamanızı sağlamak için çerezler kullanılmaktadır.
Giriş Yap
Londra Gundem ayrıcalıklarından yararlanmak için hemen giriş yapın veya hesap oluşturun, üstelik tamamen ücretsiz!